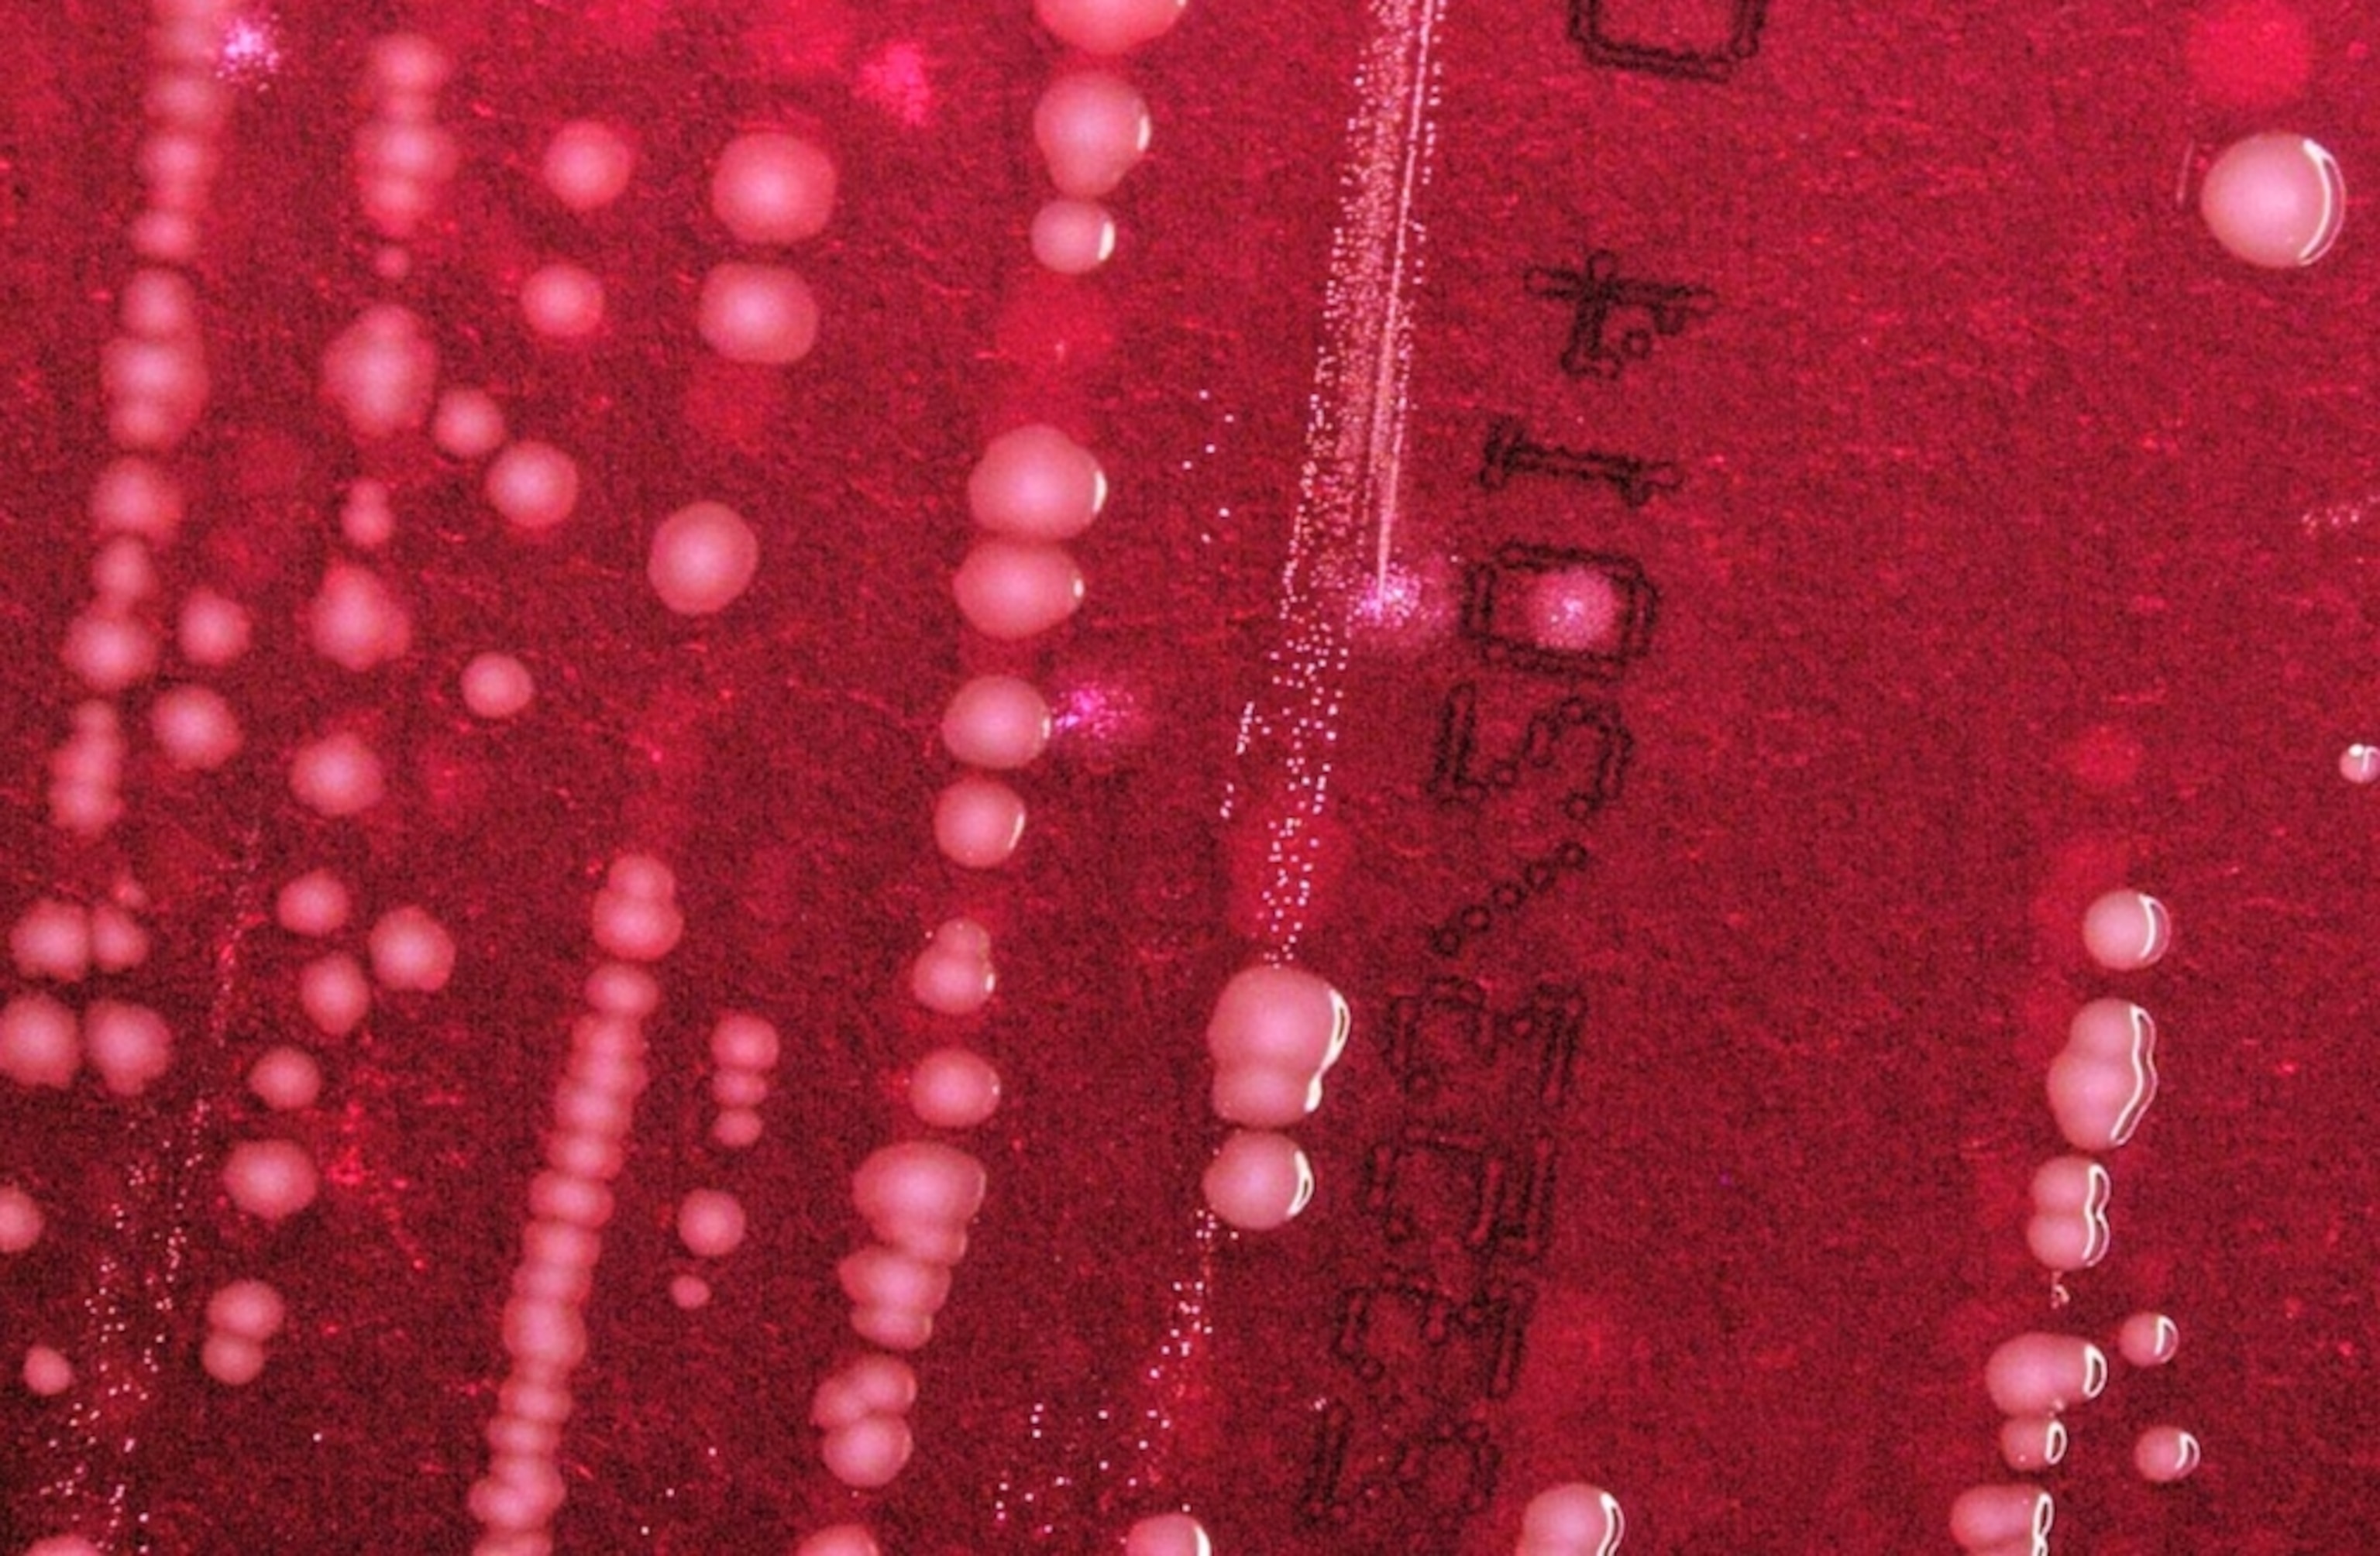

CDC Alert: Drug-Resistant Foodborne Illness Spreads in US
Figuring out how to talk about antibiotic resistance—which you’ll be seeing discussed here a lot, since it’s the topic of my last book, an important part of my next book, and a central topic in my past blogging—is a difficult balancing act. On the one hand, antibiotic resistance is a true global threat: 23,000 people die in the United States each year from resistant infections, according to the CDC, and a UK project estimates that the toll in 2050 will be 10 million deaths worldwide. On the other hand, if you’re a casual reader, alerts on antibiotic resistance probably all blur together. How can you know when a warning to be wary of this infection is more or less worth listening to than a caution that we’re losing that drug?
It’s hard. I’ll try to provide guidance. (And will trust to my infectious-disease and public health readers to contribute their knowledge.) Meanwhile, this warning is worth listening to:
The Centers for Disease Control and Prevention has sounded the alarm on a common foodborne illness that has acquired a new and challenging type of drug resistance—and the discovery betrays the difficulty, not just of finding new treatments, but of tracking resistance as it moves around the world.
In its weekly bulletin, the Morbidity and Mortality Weekly Report or MMWR—which is probably the best-read publication that you have never heard of—the CDC describes the discovery of Shigella sonnei resistant to ciprofloxacin or Cipro, which was until now the go-to drug for treating it. Until very recently, almost all Shigella was susceptible to Cipro, but since last May, this newly resistant strain has caused 243 cases of illness in 32 states and also in Puerto Rico. Some of those cases were clusters—45 in Massachusetts, 25 in California, 18 in Pennsylvania—and some were outbreaks in specific groups: homeless people, and kids in day care.

Shigella is very common, with more than a half-million cases in the US every year; it’s an illness that exists only among people, and is passed person to person rather than originating in animals or meat the way Salmonella does. (“Person to person” means what public health people delicately call the “the fecal-oral” route. Or, bluntly, that because someone with the disease didn’t wash their hands well, and then touched a door knob that you subsequently turned or a lettuce leaf that you subsequently ate, you end up swallowing their fecal bacteria. Yep.)
It causes fever and bloody diarrhea, and though people who contract it often get better on their own, it is so unpleasant and so very contagious that antibiotics are often used to end the episode faster and reduce the chances of spreading the disease. “There’s a very small infectious dose—10 bacteria are sufficient to cause infection,” Dr. Anna Bowen of the CDC told me by phone. “It’s easy to get that infectious dose onto surfaces.” (For comparison, the infectious dose of the foodborne disease Campylobacter is about 500 organisms, and Salmonella infection can require more than 1,000.)
If the bacteria don’t respond to the antibiotic given to cure a person’s case, then that person stays infectious longer, and the chances of outbreaks grows—and those outbreaks can become a significant hazard to public health. For instance: While investigating this new strain, the CDC identified a cluster of 95 cases among homeless people in San Francisco, who because of their living conditions have both obvious challenges maintaining good hygiene, and no choice about spending time in public places where they might pass the bacteria to others. “Other Shigella outbreaks we have followed over the years can reach to the multiple hundreds of people involved and can last for months and into years,” Bowen said.
Widespread outbreaks are problematic because Shigella can be a very serious illness, especially for anyone with a compromised immune system: the elderly, the very young, anyone living with HIV or undergoing cancer chemotherapy. And the changes in this strain make treatment more difficult; it has significant resistance to streptomycin, sulfa drugs, tetracycline and the drug combo known as Bactrim or Septra (trimethoprim/sulfamethoxazole or TMP-SMX) as well. “In this particular outbreak, 22 percent of patients were hospitalized,” Bowen said.
The final unsettling piece of this story is that molecular evidence gathered by the CDC and its state research partners (through a nationwide data-sharing network called PulseNet that I hope to talk about sometime) demonstrates that this resistant strain exists outside the US and was carried across borders repeatedly by travelers returning home. In an analysis of a subset of the cases, the strongest associations were to the Dominican Republic, India, and Morocco, places where access to antibiotics is less controlled than in the US, and where it’s therefore more likely that resistance will arise. (You can see those called out in the graphic above.)
This is an unsolvable vulnerability in public health: Gut carriage of organisms such as NDM, which originated in India several years ago, has allowed antibiotic resistance to spread internationally in a way that is difficult to detect or prevent. (Some hospitals in Europe check patients before admitting them, by conducting rectal swabs, but that’s not really going to work at Passport Control.) It’s a reminder that antibiotic resistance arising anywhere is a threat to people everywhere, and that it’s incumbent on all of us to use antibiotics conservatively, and to reserve them for when they are needed most.